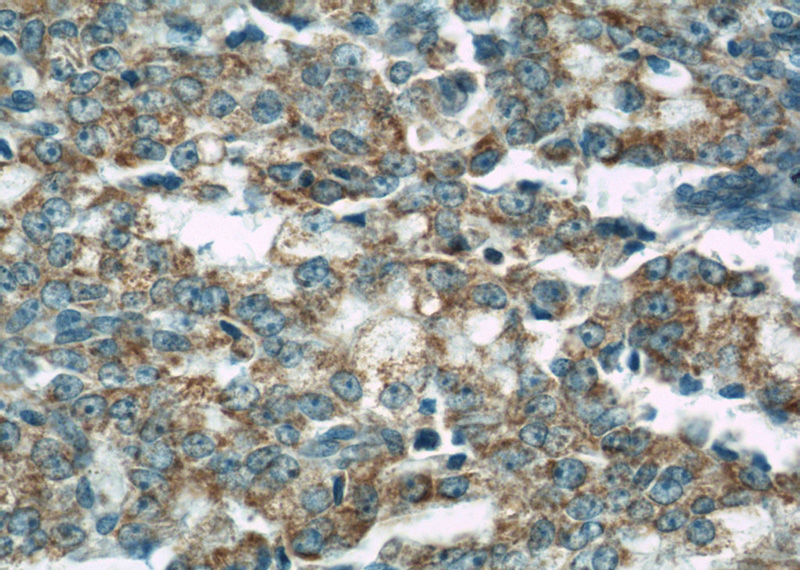
Immunohistochemical of paraffin-embedded human prostate cancer using Catalog No:107172(COXIV antibody) at dilution of 1:100 (under 40x lens)

-
Product Name
COXIV antibody
- Documents
-
Description
COXIV Mouse Monoclonal antibody. Positive WB detected in HEK-293 cells. Positive FC detected in HeLa cells. Positive IF detected in HeLa cells. Positive IHC detected in human prostate cancer tissue, human heart tissue, human pancreas tissue. Observed molecular weight by Western-blot: 17-18kd
-
Tested applications
ELISA, WB, IHC, IF, FC
-
Species reactivity
Human,Mouse; other species not tested.
-
Alternative names
COX IV 1 antibody; COX4 antibody; COX4I1 antibody; COXIV antibody; CytOChrome c oxidase polypeptide IV antibody; CytOChrome c oxidase subunit 4 isoform 1 mitOChondrial antibody
-
Isotype
Mouse IgG1
-
Preparation
This antibody was obtained by immunization of COXIV recombinant protein (Accession Number: XM_047433623). Purification method: Protein G purified.
-
Clonality
Monoclonal
-
Formulation
PBS with 0.02% sodium azide and 50% glycerol pH 7.3.
-
Storage instructions
Store at -20℃. DO NOT ALIQUOT
-
Applications
Recommended Dilution:
WB: 1:500-1:5000
IHC: 1:20-1:200
IF: 1:10-1:100
-
Validations

HEK-293 cells were subjected to SDS PAGE followed by western blot with Catalog No:107172(COXIV antibody) at dilution of 1:1000

Immunohistochemical of paraffin-embedded human prostate cancer using Catalog No:107172(COXIV antibody) at dilution of 1:100 (under 10x lens)
Immunohistochemical of paraffin-embedded human prostate cancer using Catalog No:107172(COXIV antibody) at dilution of 1:100 (under 40x lens)

Immunofluorescent analysis of HeLa cells using Catalog No:107172(COXIV Antibody) at dilution of 1:25 and Rhodamine-Goat anti-Mouse IgG

1X10^6 HeLa cells were stained with 0.2ug COXIV antibody (Catalog No:107172, red) and control antibody (blue). Fixed with 90% MeOH blocked with 3% BSA (30 min). Alexa Fluor 488-congugated AffiniPure Goat Anti-Mouse IgG(H+L) with dilution 1:1000.
-
Background
COX4I1, also named as COX4 and COXIV-1, belongs to the cytochrome c oxidase IV family. It is one of the nuclear-coded polypeptide chains of cytochrome c oxidase, the terminal oxidase in mitochondrial electron transport. COX4I1 is a marker for mitochondria. It has two isoforms (isoform 1 and 2). Isoform 1(COX4I1) is ubiquitously expressed and isoform 2 is highly expressed in lung tissues. COX4I1 is commonly used as a loading control. This antibody is specific to COX4I1 and do not cross reacts with COX4I2.
Related Products / Services
Please note: All products are "FOR RESEARCH USE ONLY AND ARE NOT INTENDED FOR DIAGNOSTIC OR THERAPEUTIC USE"
